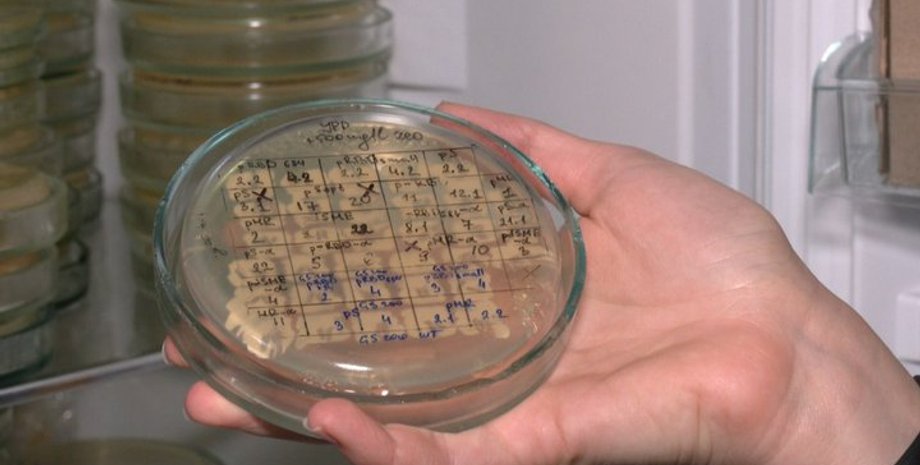
Львів, вчені, розробка вакцини від коронавируса, українська вакцина від коронавируса, COVID-19, вакцинація

Учені у Львові розробляють вакцину від коронавірусу на дріжджах (відео)
Створення препарату планують закінчити до кінця 2021 року. Втім, після цього його необхідно буде ще протестувати.
У Львові розробляють українську версію вакцини від коронавірусу. Для створення білкового препарату використовують дріжджі. Про це розповів виданню "Суспільне" директор Інституту біології клітини НАН України академік Андрій Сибірний.
За схожим принципом, за словами вченого, розробляються і закордонні вакцини.
"Такі вакцини від Новавакс (Novavax) теж білкові. Це так само білок коронавірусу, але синтезується він не в дріжджах, а в клітинах комах", — зазначив Сибірний.
Учені вирішили працювати з дріжджами через те, що вже мають позитивний досвід роботи з ними, виробляючи з них вітаміни й антибіотики.
"Я маю досвід позитивної роботи створення вакцини від гепатиту В на дріжджах. Це була робота на замовлення Національної академії медичних наук близько 10 років тому від однієї американської фірми. І ми маємо один з найкращих продуцентів тієї вакцини серед усіх відомих продуцентів на дріжджах", — повідомив Сибірний.
За словами академіка, на сьогодні вони вже нібито пройшли початкові етапи в створенні вакцини і до кінця року планують закінчити розробку. Втім, пізніше її ще необхідно буде протестувати. Білки вірусу планують тестувати на тваринах.
"Ось цей останній етап роботи, напевно, доведеться проводити з нашими колегами в Польщі. Так ми попередньо домовилися. Я б хотів, щоб це була повністю українська вакцина, але судячи з усього, це буде міжнародне співробітництво" — сказав Сибірний.
Зазначається, що під час розробки у вчених з'явилася ідея розробити ще одну вакцину від COVID-19, цього разу — у формі таблеток.
"Ідея така, що білок буде на поверхні дріжджів. Дріжджі самі не будуть імуногенні, білок буде викликати імунну реакцію і можна буде створити таблетку, яка б містила ці дріжджі", — розповіла Марта Семків, науковий співробітник відділу молекулярної генетики та біотехнологій.
У минулому році Інститут біології клітини НАН України переміг у конкурсі грантів від Національного фонду наукових досліджень. Так, на розробку вакцини від коронавірусу львівські вчені отримали майже 10 млн грн.
Нагадаємо, що 22 жовтня 2020 року президент України Володимир Зеленський розповідав про унікальну українську вакцину. Її розробкою займалися понад півроку. 26 жовтня 2020 року міністр охорони здоров'я Максим Степанов повідомив, що оригінальна українська вакцина від COVID-19 може з'явитися через рік.
Втім, 16 квітня 2021 року голова парламентського Комітету з питань здоров'я нації Михайло Радуцький заявив, що "розробка української вакцини від коронавірусу на нульовому етапі".
